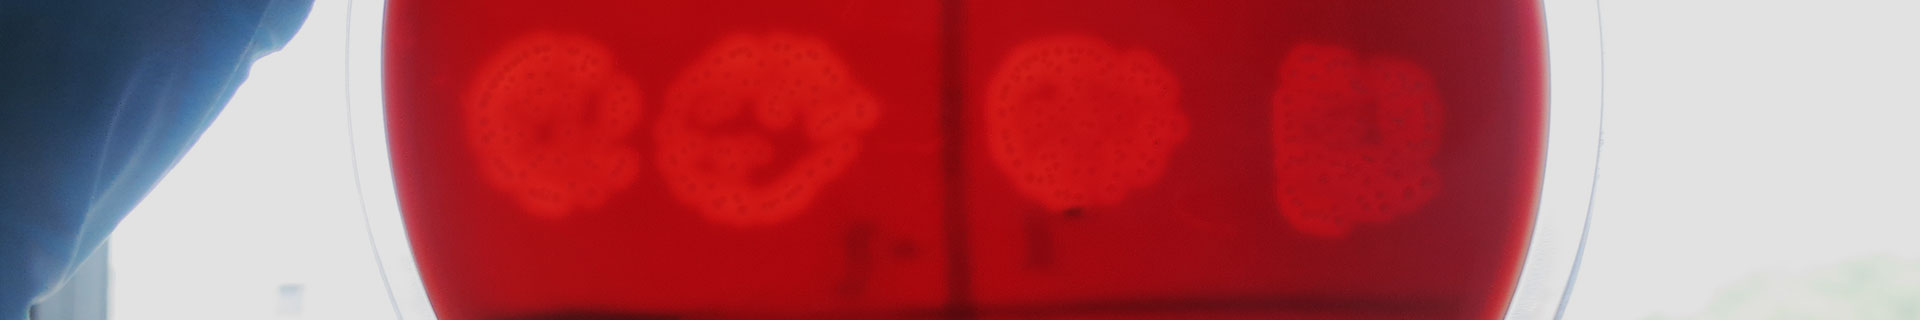

Who are we?
The PERISCOPE (PERtussIS COrrelates of Protection Europe) consortium brings together internationally renowned scientists with many years of experience in Bordetella pertussis (Bp) research, clinical trials, bioinformatics, immunology and public health. PERISCOPE combines two major industrial partners with public researchers from academic and public health institutes and SMEs with expertise in clinical trials, vaccinology, immunology, molecular microbiology, (human) challenge models and bioinformatics.
Why are we doing this?
Globally, there are 16 million pertussis cases and about 195,000 pertussis deaths in children per year (estimates by CDC), making it one of the leading causes of vaccine-preventable deaths. The WHO has recommended more extensive vaccination in low income countries and in particular the implementation of maternal immunization programs to protect infants who are most vulnerable to pertussis.
pertussis cases globally
pertussis deaths in children per year
Who is funding us?
The Innovative Medicines Initiative (IMI) is a partnership between the European Union and the European pharmaceutical industry, represented by the European Federation of Pharmaceutical Industries and Associations (EFPIA). Through the IMI 2 programme, IMI has a budget of € 3.3 billion for the period 2014-2024. Half of this comes from the EU’s research and innovation programme, Horizon 2020. The other half comes from large companies, mostly from the pharmaceutical sector; these do not receive any EU funding, but contribute to the projects ‘in kind’, for example by donating their researchers’ time or providing access to research facilities or resources.
Within PERISCOPE, the European Union and the European Federation of Pharmaceutical Industries and Associations (EFPIA) invest € 21mio and the Bill & Melinda Gates Foundation an additional € 7mio, giving a total of € 28mio over the next five years.
EU and EFPIA
with support of the Bill & Melinda Gates Foundation